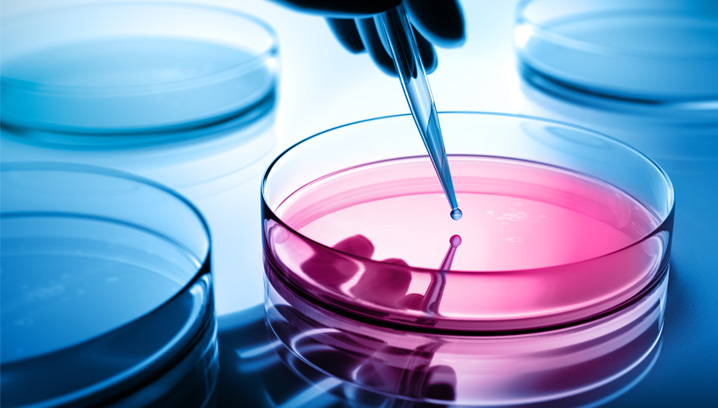
Cyber-Schutz für Krankenhäuser und Kliniken

Pandemie: Die Welt im Ausnahmezustand
Wenn eine Infektionskrankheit nicht nur lokal auftritt, sondern mehrere Länder und Kontinente erfasst, spricht man von einer Pandemie. Die Folgen: Menschen fürchten um ihre Gesundheit, Regierungen schalten in den Krisenmodus und Unternehmen brauchen dringend einen Notfallplan.
Durch die weltweite Vernetzung von Lieferanten, Produzenten und Absatzmärkten gibt es kaum ein Unternehmen, das nicht von den Folgen einer Pandemie betroffen ist. Unternehmen auf der ganzen Welt schließen ihre Betriebe entweder ganz, schrauben die Produktion herunter oder versuchen, die Belegschaft im Home Office zu isolieren, um eine weitere Verbreitung des Virus zu verlangsamen. Durch die Schließung von Ländergrenzen geraten Lieferketten in Gefahr, was zu Betriebsunterbrechungen führen kann. Warenlieferungen hängen in Häfen fest, Forderungen werden nicht bedient und wichtige Veranstaltungen fallen aus. Kurzum: Es herrscht Ausnahmezustand – der sehr schnell die Existenz bedrohen kann. Wir geben einen Überblick über das Versicherungs- und Risikomanagement in Krisenzeiten.
Beiträge zu Versicherungs- und Risikomanagement

Auslandsreise-Krankenversicherungen
Internationale Aufträge im Spannungsfeld
Um den Fortbestand des Unternehmens zu sichern sowie die eigenen Mitarbeitenden zu schützen, bedarf es eines vollen Versicherungsschutzes, der auch bei Reisewarnungen gilt.
Mehr erfahren
Wie Sie Forderungen richtig absichern
Das Coronavirus rüttelt die Wirtschaft kräftig durch. Für Lieferanten kann es deshalb sinnvoll sein, sich mit einer Warenkredit-Versicherung gegen die Insolvenz von Abnehmern zu wappnen.
Mehr erfahren
Was Unternehmen jetzt tun sollten
Die Ausbreitung des Coronavirus hinterlässt auch in der Wirtschaft tiefe Spuren. In vielen bereits vor der Krise gebeutelten Branchen verstärkt sie den Abwärtstrend. Umso wichtiger ist es für Unternehmen, jetzt schnell und konsequent das Richtige zu tun. Das gilt auch für das Versicherungs- und Risikomanagement.
Zur Ausgabe
Betriebsstilllegung infolge des Coronavirus
Mit der vorübergehenden Betriebsstilllegung infolge des Coronavirus, ausgelöst durch behördliche Anordnung oder zum Schutz der Mitarbeiter, fallen in der Regel die produktionsspezifischen und geschäftsbezogenen Risiken vorübergehend weg. Vor Ort können hierdurch zusätzliche Gefahrenpotenziale entstehen.
Mehr erfahren
Der österreichische Versicherungsmarkt 2020
Die Coronapandemie beschleunigt die Verhärtung der ohnehin schon angespannten Versicherungsmärkte. In den Bilanzen der Versicherer hat Covid-19 zu einer deutlichen Ergebnisbelastung geführt.
Mehr erfahren
Gutachten und Finanzierungen in Zeiten von Corona
Die Coronakrise macht auch vor der betrieblichen Altersvorsorge keinen Halt. Unternehmen sollten daher die Entwicklung der Zins- und Kapitalmärkte auch hinsichtlich der Pensionsrückstellungen und der damit verbundenen Erstellung der versicherungsmathematischen Gutachten nicht aus den Augen verlieren.
Mehr erfahren
Szenarien für die Wirtschaft in der Coronakrise
Wie lange wird das Coronavirus die Wirtschaft lähmen? Wir stellen verschiedene Shutdown-Szenarien vor, werfen einen Blick auf die betroffenen Branchen und geben Unternehmen Tipps, welche Themen jetzt auf der Agenda stehen sollten.
Mehr erfahren
Checkliste Handlungsempfehlungen: Notfallplan als Download
COVID-19 fordert schnelles und überlegtes Handeln. Unsere Checkliste für Unternehmen fasst die wichtigsten organisatorischen und operativen Maßnahmen zusammen und bildet eine mögliche Hilfestellung für Ihre Notfallplanung.
Jetzt herunterladen
Was die Immobilienbranche jetzt tun sollte
Die Ausbreitung des Coronavirus hinterlässt in der Wirtschaft tiefe Spuren. Auch die Immobilienbranche ist von den Auswirkungen direkt betroffen.
Zur Ausgabe
Cyberschutz für Krankenhäuser und Kliniken
Die Coronakrise hat viele gewohnte Arbeitsprozesse auf den Kopf gestellt. Das ist ein Einfallstor für Cyber-Kriminelle – auch in Krankenhäusern und Kliniken.
Mehr erfahren
Auswirkungen des Coronavirus bei Auslandsreise-Krankenversicherungen
Arbeitgeber in Österreich tragen für Auslandstätigkeiten und Dienstreisen seiner Mitarbeiter ins Ausland eine besondere Verantwortung. Die Fürsorgepflicht des Arbeitgebers ist gesetzlich geregelt.
Mehr erfahren
Das Coronavirus und die Gesundheitswirtschaft
Die rasende Ausbreitung des Coronavirus und die steigende Zahl von Infektionen in Österreich beunruhigen viele Menschen. Besonders betroffen ist die Gesundheitswirtschaft, von der Hochleistungen verlangt werden. Ein Überblick über die Lage am Versicherungsmarkt.
Mehr erfahren
